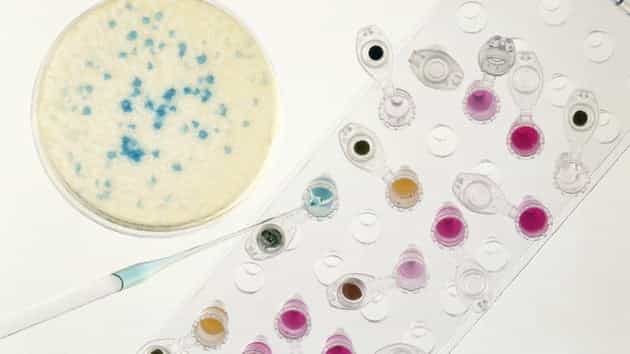
Una nueva bacteria resistente a los antibióticos amenaza a la humanidad

Biólogos y médicos advierten que cada vez son más las bacterias resistentes a los antibióticos. Entre ellas la bacteria patógena humana KPC-Oxa 48, invulnerable a cualquier antibiótico conocido, que se llevó la vida de un hombre en Nueva Zelanda.
La bacteria KPC-Oxa 48 infectó a un ciudadano de Nueva Zelanda durante una estancia en Vietnam. Brian Pool, de 68 años, trabajaba en ese país asiático como profesor de inglés.
El microbiólogo Mark Jones, del hospital de Wellington, que estudia esta superbacteria dijo en un comunicado que “nunca hemos visto tal bacteria no sensible a los antibióticos existentes, incluso a los más fuertes. Por primera vez nos enfrentamos a un microorganismo resistente a todos los antibióticos. Absolutamente nada le puede hacer frente”.
Los científicos confiesan que en esta etapa del desarrollo de la ciencia no saben cómo combatir esta bacteria, y que solo tratan de luchar contra los síntomas, algo que tampoco tiene mucha eficacia. Mientras esté vivo el patógeno los síntomas no desaparecerán, advierten los expertos.
Según los microbiólogos, la humanidad está entrando en una nueva era, la del postantibiótico. Entre las posibles causas de la aparición de nuevas superbacterias patógenas se baraja el uso excesivo de antibióticos por cualquier razón, pero puede ser que haya otros factores.
La doctora Sally Davies, principal asesora del Gobierno Británico en temas de salud, alertó en enero pasado sobre el hecho de que las bacterias se están volviendo resistentes a los medicamentos actuales y que existen pocos antibióticos que puedan ser realmente efectivos. Esta tendencia es una “amenaza global catastrófica” que debe ser colocada en primer término junto con el terrorismo, sostuvo.